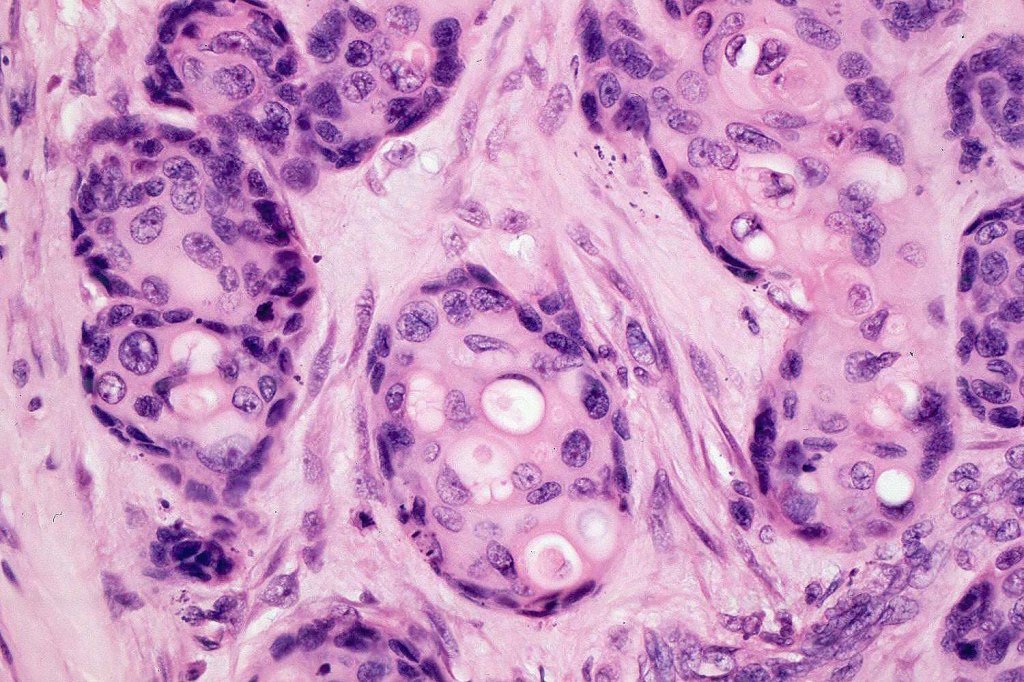
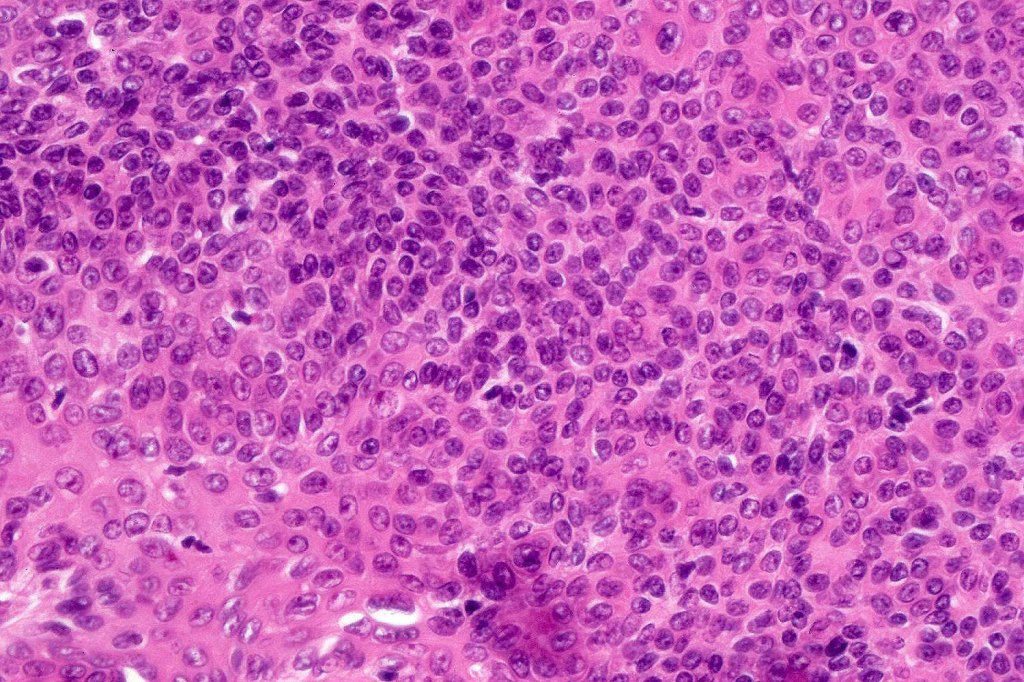
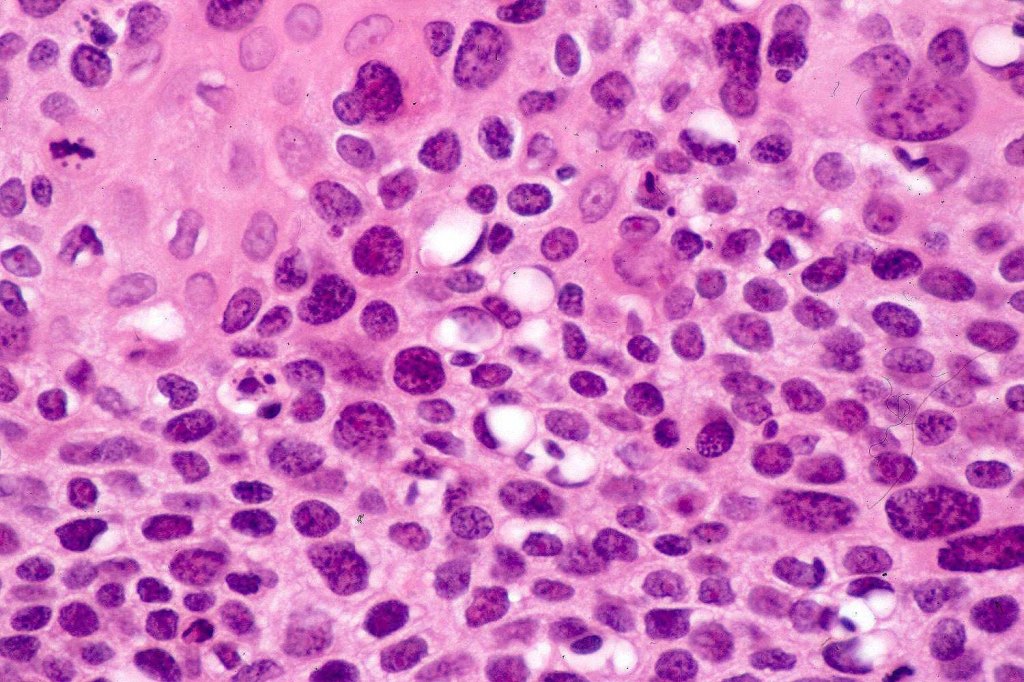

Clinical features
•Slight predilection for males
•1.9 per 100,000 person years
•Wide age range (8-91, median 73)
•May arise in an eccrine poroma (11%)
•Exceptionally complicates nevus sebaceus
•Lower limb (44%)> trunk (24%)> head (18%) and upper limb (11%)
•Sometimes ulcerated verrucous plaque
•Recurrences (17%), nodal metastases (19%), systemic spread (11%), mortality (7-11%)
Histological features
•Association with UVB and immunosuppression
•In situ (malignant hidroacanthoma simplex)
•Continuity/origin from epidermis (arises from the acrosyringium, distinguishes this tumor from hidradenocarcinoma)
•Pushing or infiltrating deep margin
•Broad anastomosing epithelial trabeculae
•Variable nuclear pleomorphism
•Some tumors are deceptively bland & diagnosis depends upon growth pattern or is made in retrospect after metastasis
•Mitoses often conspicuous and sometimes abnormal
•Variable necrosis (may be comedo-like)
•Variable lymphovascular invasion
•Variable perineural infiltration
•Ducal differentiation invariably present
•Intracytoplasmic lumina
•Squamous differentiation
•Apocrine, clear cell, Bowenoid, pigmented & sarcomatoid (metaplastic) variants
•Exceptionally shows eccrine syringofibroadenoma-like foci
•Metastases are sometimes epidermotropic

Immunohistochemistry
•CK5, CK7, CK19, Cam 5.2, CD117, BerEP4, CEA & EMA +ve (Images from Dr. Conti’s case)
•Merkel cell polyomavirus is probably a passenger virus rather than representing an oncogenic driver



Please subscribe to the blog and like (if you enjoyed this blog)
Leave a comment